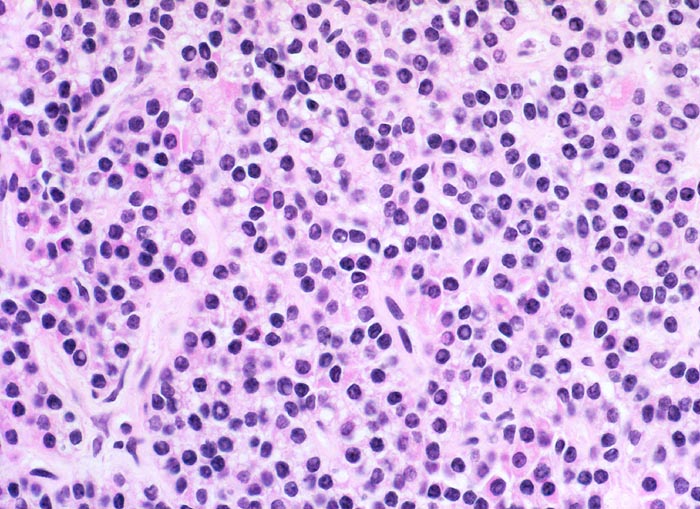

PathoPic – image database / PathoPic ID 5091 - noduläre Nebenschilddrüsenhyperplasie: Hauptzellen
de
Diagnose
noduläre Nebenschilddrüsenhyperplasie: Hauptzellen
Diagnose Gruppe
Systemerkrankung/Immunpathologie
Topographie
Nebenschilddrüse
Topographie Gruppe
Endokrinium
Beschreibung
Ausschnitt aus einem hyperplastischen Knoten bestehend aus überwiegend aktiven dunklen Hauptzellen mit kleinen runden chromatindichten Kernen.
Klinik
Der Patient leidet an einer chronischen Niereninsuffizienz. Die glomeruläre Filtrationsrate ist auf 25% reduziert. Unter anderem ist eine Hypokalzämie und eine Hyperphosphatämie vorhanden. Die Serumkonzentration des Parathormons ist erhöht. Die Diagnose eines sekundären Hyperparathyreoidismus wird gestellt.
Bilder Typ
Histologie
Vergrösserung
400
Alter
62
Geschlecht
männlich
Datum
Ersteintrag: 06.07.2002